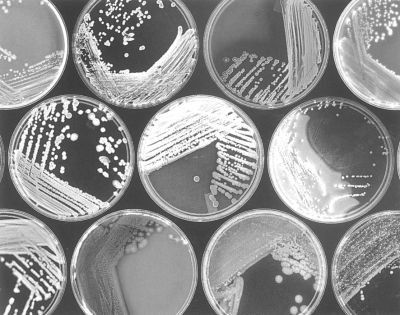
护肤这么多年，这10个冷知识你还不知道？

护肤这么多年,这10个冷知识你还不知道?
我们的脸,是给外人的第一印象。一张光滑好看的脸,能让你有趣的灵魂更先一步为人所知,那么科学护肤的重要性,就显而易见了。
为了更清晰地了解自己的皮肤,小编为大家整理了10个冷知识,一起来记一记吧~
文章插图
1.护肤品不分男女
不管男女,皮肤PH值都是酸性的,护肤品也是酸性到中性的,不用刻意追求男士品牌。
女朋友的神仙水——可以用,女朋友的海蓝之谜——可以用。
(奔跑吧!兄弟)
文章插图
2.下雪天需要严格防晒
新雪的紫外线反射率高达80%,基本上就等于天上一个太阳,地上一个太阳。
你就夹在中间,如果不严格防晒,也就差不多“煎至两面金黄”的状态了!
3.面膜只有补水这一个功能
面膜千万种,有修复有美白,但其实只有一个用处,就是补水。
通过浸湿角质层、形成封闭膜,面膜能使皮肤看起来水嫩剔透,甚至有变白的错觉。
文章插图
4.隔离霜不是防毒面具
隔离霜能隔离彩妆、隔离雾霾、隔离蓝光?别搞笑啦!
隔离霜本身也是彩妆,涂一个硬币大小的用量也就能抵SPF7的防晒霜,其他功效更是免谈。
所以,防晒霜一定要涂,隔离霜嘛~用不用随意。
文章插图
5.冷热水交替洗脸,并不能收缩毛孔
理论上,冷敷后随着毛囊皮脂腺单位的冷缩,确实有那么短短一刻,毛孔是缩小的。
但最终,毛孔会还原,一切是徒劳。(收缩毛孔的护肤品也一样)
6.护肤品不存在“活酵母”
护肤品用的关于菌类的原料,不是滤液就是微生物产物,并不存在有活的微生物。
如果真的有,
在微生物检测那一关就过不了了
,不要再被骗啦!
文章插图
7.抹护肤品不要“啪啪啪”
“啪啪啪”拍脸并不能促进吸收,相反,会把刚涂上的护肤品飞溅出去,加快流失。
对于敏感肌,扩张的血管在拍打和摩擦时会受到进一步的刺激,造成敏感泛红。
8.长痘时少吃奶制品
辣椒会致痘已经辟谣了。
但
奶制品会致痘却是真的
!牛奶中含有IGF-1(促生长因子),可以促进皮肤的油脂分泌,经过巴氏消毒也不会失去活性。
文章插图
?9.吃、涂胶原蛋白,都没用
胶原蛋白是大分子结构有机物,无法进入毛孔。
吃掉的胶原蛋白会被蛋白酶分解成氨基酸,也补充不了脸上的胶原。
【护肤这么多年,这10个冷知识你还不知道?】(别折腾了!姐妹)
10.孕妇可以正常护肤
只要是正规产品,孕妇就可以用,不需要区分孕妇专用护肤品。
除非你孕期肌肤敏感,否则,都可以正常使用护肤品。
文章插图
推荐阅读
- 李易峰|满脸褶子、眼神猥琐,明明都这么老了,就别硬尬“少年感”了
- 时尚搭配|娱乐圈里没几个人能像卢靖姗这么穿衣服,复古造型很有个性感
- 逆局|神似宁静,但两人的发展却相差很大,多次搭档都是大咖,可惜多年不温不火!
- 甄嬛|为什么安陵容晋封妃位的头饰这么简单,跟甄嬛和华妃的差了好多?
- 古力娜扎|同是西域绝色的女明星,为什么她却被群嘲那么多年?
- 梁锦松|奶奶不同意孙女嫁豪门,她却坚持这么做,如今丈夫70岁儿子才14岁
- 王骁|原来他是“隐藏”星二代,低调拍戏多年不拼爹,难怪他这么出色!
- 周深|周深的教养刻在了骨子里,从一个举动能证明,难怪这么多人喜欢他
- 郭富城|媒体问郭富城:你每月给方媛一家都不超过100万,怎么这么抠门?
- 申惠善|对不起!真的不知道原来你们有这么高...
















